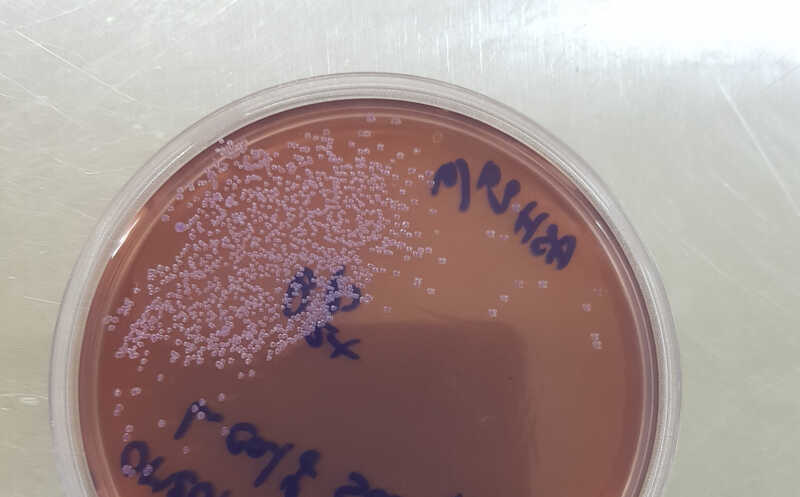

Крупномасштабное исследование геномов изолятов Haemophilus influenzae из разных стран продемонстрировало малое генетическое разнообразие этого возбудителя разнообразных детских инфекций. Это подтверждает возможность создания универсальной вакцины против H. influenzae что особенно важно на фоне другой находки — авторы показали, что у данной бактерии широко распространена устойчивость к антибиотикам. Необходимо расширять охват H. influenzae глобальными системами мониторинга, подчеркивают авторы.
Изображение:
Колонии H. influenzae на агаровой среде.
Credit:Paul Turner | пресс-релиз
Авторы статьи в журнале Nature Microbiology продемонстрировали малое генетическое разнообразие изолятов Haemophilus influenzae по всему миру. Это означает, что против нее возможно создать универсальную вакцину.
Бактерия Haemophilus influenzae (название связано с тем, что ее ошибочно считали возбудителем гриппа) обитает в носоглотке человека и является частью ее нормальной микрофлоры. Однако H. influenzae способна транслоцироваться в другие части тела, такие как внутреннее ухо, легкие и носовые пазухи, и вызывать заболевания. Например, острый средний отит (ОСО) — одна из основных причин назначения антибиотиков детям. По глобальным оценкам, более 700 миллионов случаев ОСО в год вызываются различными бактериальными патогенами, и значительная часть из них приводит к дальнейшим осложнениям, особенно в странах с низким и средним уровнем дохода.
Существует вакцина против H. influenzae типа b (Hib), созданная на основе конъюгата полисахарида с белком в конце 1980-х годов и включенная в национальные программы вакцинации во всем мире. Ее применение снизило число случаев детского менингита и пневмонии. Однако данная вакцина не защищает от колонизации другими серотипами или неинкапсулированными нетипируемыми H. influenzae (NTHi) — возбудителей синуситов, конъюктивитов и пневмонии. При этом у некоторых штаммов NTHi наблюдается устойчивость к антибиотикам.
Генетическая структура популяции H. influenzae и ее эволюционная динамика изучены слабо. Международная команда ученых секвенировала 4 474 образца, взятых из носоглоток новорожденных детей, которые находились в лагере для перемещенных лиц Маэла (северо-запад Таиланда). В исследование также включили 5 976 опубликованных геномов H. influenzae, чтобы составить глобальную картину эволюции и эпидемиологии патогена. Таким образом, проведено первое крупномасштабное исследование геномов H. influenzae.
Все дети, являющиеся носителями H. influenzae, были колонизированы преимущественно NTHi, несмотря на то, что они не были иммунизированы против Hib. Из более чем 3900 изолятов 91,7% принадлежали NTHi, серотип b составил 5,7%; остальные серотипы встречались крайне редко. Результаты типирования капсулы in silico совпадали с серологическим в 95,3% случаев, небольшие расхождения авторы объясняют более широким, чем в предыдущих исследованиях, разнообразием геномов. Распределение серотипов было схожим у пациентов с пневмонией и без нее. Анализ генетической структуры также не выявил специфических линий, связанных с пневмонией, при этом в популяции преобладали нетипируемые штаммы.
Анализ детерминант антимикробной резистентности показал, что устойчивость часто встречается среди различных филогенетических линий H. influenzae и в основном связана с мультирезистентными (MDR) штаммами. Из всех MDR-линий только одна была серотипа b, остальные относились к NTHi. Авторы показали, что MDR-штаммы многократно и независимо друг от друга приобретали гены устойчивости. При этом, несмотря на распространенность NTHi, серотип b был значительно более антибиотикорезистентным. Доля MDR-изолятов, выявленных при пневмонии, составила 17% (в основном NTHi), а при других инфекциях — 15,6%, т.е. распределение MDR между типами инфекций было примерно одинаковым.
Чтобы оценить роль горизонтального переноса генов в распространении устойчивости к антибиотикам, исследователи проанализировали уровень гомологичной рекомбинации у H. influenzaeна уровне отдельных генов пангенома. События рекомбинации обнаружены в 38% генов (2672 из 7015), в среднем — около 193 событий на ген. Частота рекомбинаций коррелировала с нуклеотидным разнообразием (при этом у генов без рекомбинации нуклеотидное разнообразие было нулевым). Дополнительный анализ показал, что разделение однонуклеотидных полиморфизмов (SNP) в зависимости от расстояния между парами оснований происходит у H. influenzae быстрее, чем у других склонных к рекомбинации видов (например, у Campylobacter jejuni и Enterococcus faecalis). Авторы предположили, что из-за чрезвычайного уровня рекомбинации у H. influenzae снижен общий уровень разнообразия внутри популяции.
Для сопоставления разнообразия изолятов Маэлы с глобальной популяцией исследователи расширили выборку, включив в анализ суммарно 9 849 изолятов H. influenzae. Кластеризация выявила 752 эволюционные линии, среди которых большинство крупных кластеров включали свыше 100 изолятов, а большинство остальных — менее 10. Крупные кластеры были в большинстве своем парафилетическими, а небольшие или одиночные кластеры — монофилетическими. Филогенетический анализ показал, что изоляты Маэлы широко распространены в глобальной популяции, причем ключевые гены в глобальной выборке характеризовались меньшим разнообразием, чем дополнительные.
Чтобы понять, как отбор влияет на генетическое разнообразие, исследователи рассчитали отношение числа несинонимичных замен к числу синонимичных (dN/dS) для всех генов пангенома. Это указало на преобладание негативного отбора, отбраковывающего изменения. Лишь в 4% генов обнаружились признаки положительного отбора, в их числе безымянный транспортер глюконата, токсин BrnT и небольшой белок с неизвестной функцией. Во всех них имелись уникальные варианты, чаще встречающиеся в изолятах Маэла, что может отражать локальную адаптацию. Анализ MDR-линий выявил три наиболее крупные распространенные как минимум в 11 странах. Одна из них связана с серотипом b, а две другие — с NTHi.
По словам доктора Нила Макаласдера из Европейского института биоинформатики EMBL (EMBL-EBI), соавтора исследования, данная работа «закладывает основу знаний о генетическом разнообразии всего вида относительно штамма, против которого у нас есть вакцина. Хотя H. influenzae отличается интенсивной рекомбинацией, существуют эволюционные процессы, сохраняющие большую часть генома. Более глубокое понимание этих консервативных участков может стать ключом к созданию эффективной вакцины, которая предотвратит заболевания, вызываемые всеми штаммами H. influenzae, и снизит нашу зависимость от антибиотиков широкого спектра действия».
Трехвалентная вакцина против сальмонеллы прошла первую фазу КИ
Источник
Neil MacAlasdair, N. et al. Genetic population structure of Haemophilus influenzae at local and global scales. // Nature Microbiology (2025), Published Online 31 October, 2025. DOI: 10.1038/s41564-025-02171-9
Цитата по пресс-релизу